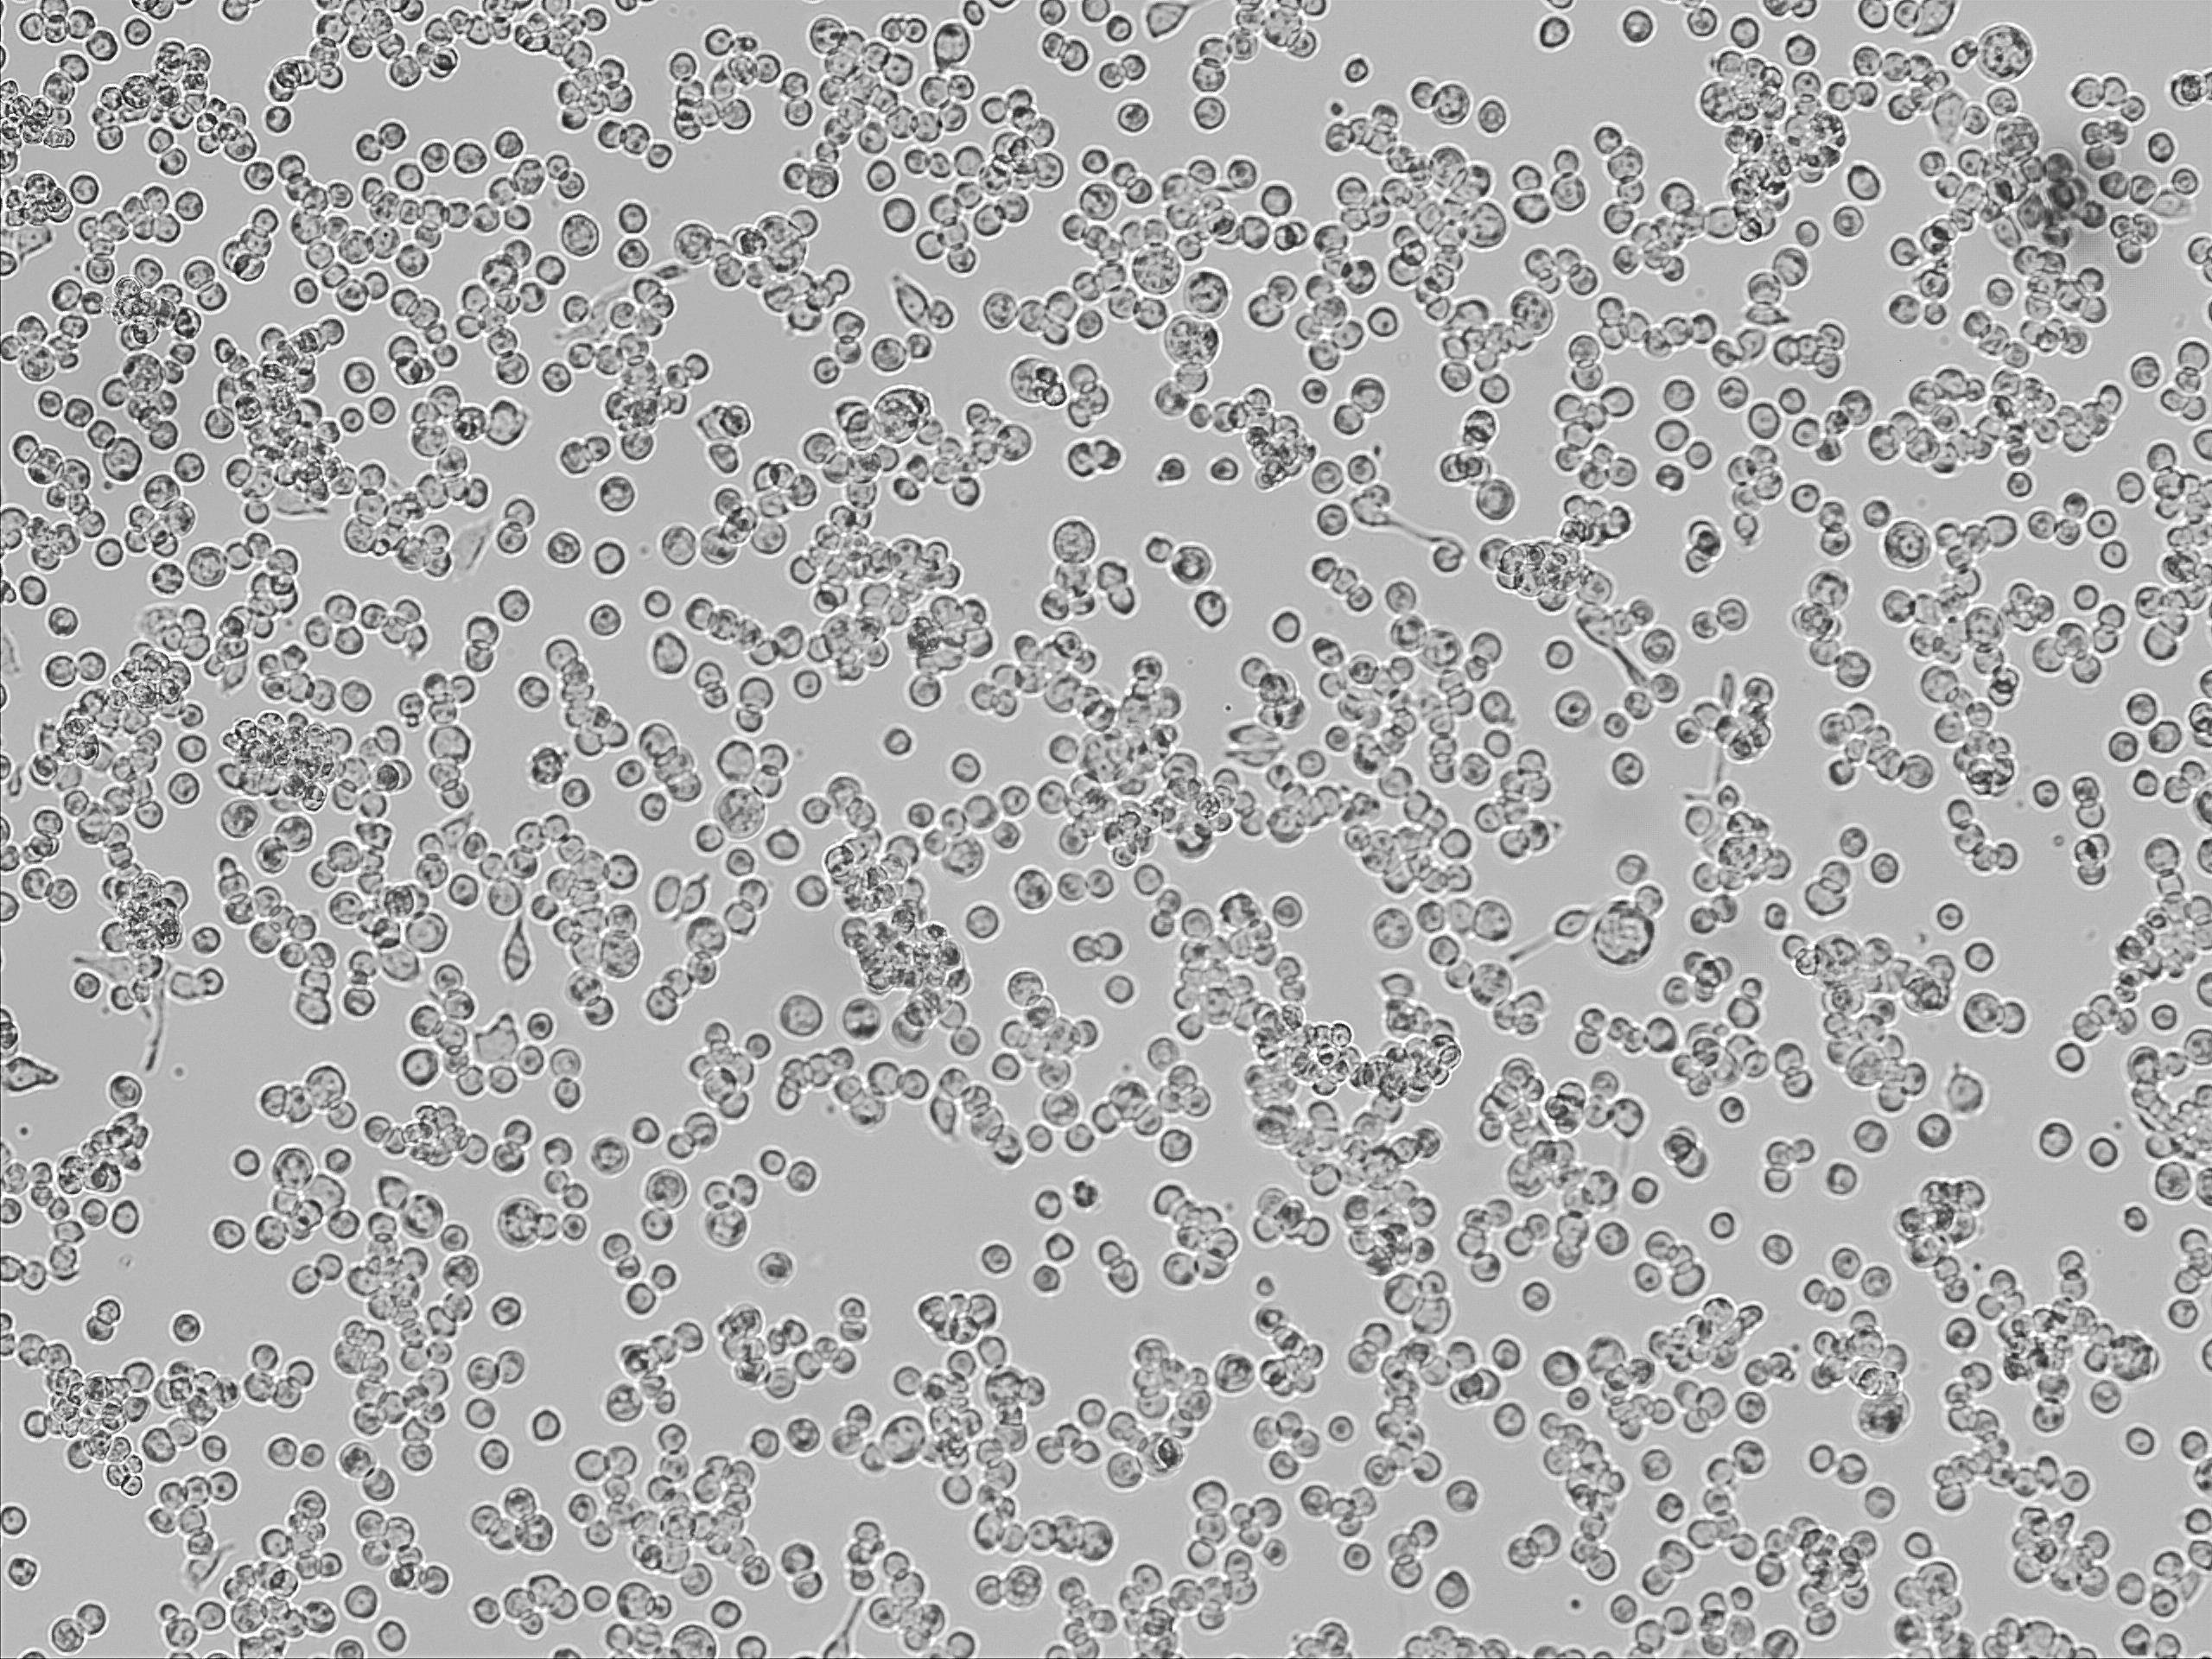
懸浮細(xì)胞

懸浮細(xì)胞培養(yǎng)常見問題處理解決方法
發(fā)布時(shí)間:2023-04-18 瀏覽次數(shù):417
懸浮細(xì)胞大多胞體呈圓形,不貼于支持物上,呈懸浮生長,容易大量繁殖。懸浮細(xì)胞培養(yǎng)雖比貼壁細(xì)胞少了消化的步驟,但培養(yǎng)起來同樣不易。有碎片、形態(tài)改變、生長速度慢、細(xì)胞貼壁……每一種異常都牽動著我們的心。
因此本期細(xì)胞學(xué)堂整理了懸浮細(xì)胞收貨和培養(yǎng)過程中的常見問題,并針對各個(gè)問題列出解決辦法,帶你逐個(gè)擊破!
運(yùn)輸常見問題及處理方法
1 碎片多
處理方法:懸浮細(xì)胞受到運(yùn)輸或者其他因素導(dǎo)致細(xì)胞損傷時(shí),容易產(chǎn)生細(xì)胞碎片,碎片可通過低速離心(800~1000rpm,3min)去除;低速離心同時(shí)也會丟失細(xì)胞,故細(xì)胞密度低的時(shí)候不適用,細(xì)胞密度低時(shí)應(yīng)正常轉(zhuǎn)速離心,保留細(xì)胞優(yōu)先。
2 細(xì)胞不圓/形態(tài)變了/聚團(tuán)
處理方法:懸浮細(xì)胞受到運(yùn)輸或者微環(huán)境變化影響時(shí),可能出現(xiàn)變形,聚團(tuán)等現(xiàn)象,在使用正確培養(yǎng)基和操作都正確的情況下,一般繼續(xù)培養(yǎng)一周左右可以恢復(fù)原狀。
培養(yǎng)過程常見問題及處理方法
1 細(xì)胞不圓/形態(tài)變了/聚團(tuán)
處理方法如下:
? 少量細(xì)胞聚團(tuán)、呈葡萄串狀,屬于正?,F(xiàn)象,特別是細(xì)胞密度較低時(shí),易出現(xiàn)這種情況。通過靜養(yǎng)(少操作,少觀察) 、補(bǔ)加血清(5%)等方式,讓細(xì)胞密度增高逐漸適應(yīng)環(huán)境后可以恢復(fù)正常;
? 血清品牌會影響細(xì)胞生長狀態(tài),如果一種不會聚團(tuán)的細(xì)胞,養(yǎng)出來全部聚團(tuán),分散的細(xì)胞很少,這時(shí)候要考慮血清的影響。
2 細(xì)胞生長慢或不生長
處理方法:懸浮細(xì)胞有密度依賴性,在高密度下狀態(tài)比較好,低密度時(shí)狀態(tài)較差,所以傳代比例要控制,細(xì)胞狀態(tài)不好時(shí),傳代可以不用離心法,而是補(bǔ)液或者半換液的方式,以避免離心損失細(xì)胞。
3 細(xì)胞發(fā)生貼壁
處理方法如下:
? 細(xì)胞培養(yǎng)瓶靜置時(shí)間太長,細(xì)胞沉底后會出現(xiàn)少量貼壁現(xiàn)象,但這種貼壁非常松,吹一下或拍一下細(xì)胞就可以起來;此現(xiàn)象為正?,F(xiàn)象,無需特殊處理。
? 如果細(xì)胞貼的非常緊,形態(tài)已經(jīng)變成類似于上皮樣時(shí),需考慮是否為細(xì)胞特性或者有其他因素刺激導(dǎo)致;
? 日常操作避免染菌以及使用優(yōu)質(zhì)血清是預(yù)防懸浮細(xì)胞貼壁的有效方法
培 養(yǎng) 小 貼 士
1 懸浮細(xì)胞常規(guī)推薦接種密度:3-5×105cell/mL,生長到2×106cell/mL左右可繼續(xù)傳代;該密度建議為理論值,實(shí)際按照每個(gè)細(xì)胞特性有波動;
2 培養(yǎng)懸浮細(xì)胞需要穩(wěn)定的生長環(huán)境,少操作,少觀察,更有利于細(xì)胞生長;
3 不建議將聚團(tuán)的細(xì)胞頻繁吹散,等待密度高和狀態(tài)改善時(shí),細(xì)胞會自行散開;部分細(xì)胞聚團(tuán)生長為特性,吹散不利于生長,請注意查看相關(guān)培養(yǎng)說明;
4 有些細(xì)胞本身就是聚團(tuán)生長(NK92,NK92MI,JURKAT,H209,ATT20等),有些細(xì)胞本身就形態(tài)不圓(H9等),為正?,F(xiàn)象,無需特殊處理;
5 豎瓶培養(yǎng)可以促進(jìn)細(xì)胞生長,但由于拿出來觀察時(shí)都是橫瓶,觀察久了細(xì)胞會貼到底部,觀察完再次豎起來就會有細(xì)胞掛在瓶底部,而細(xì)胞沒有培養(yǎng)基滋潤很快就會死掉并殘留在壁上,從而導(dǎo)致養(yǎng)著養(yǎng)著細(xì)胞越來越少,貼壁細(xì)胞越來越多;因此,在培養(yǎng)瓶豎置操作時(shí)需注意吹下培養(yǎng)瓶底部的細(xì)胞,避免細(xì)胞殘留。

說明:轉(zhuǎn)載只為分享目的,如有侵權(quán)請聯(lián)系刪除,謝謝!
